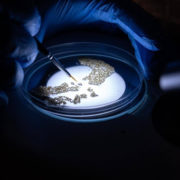

By Cathy Smith, Managing Director at SAP Africa
Championing the cause of technology as a business value driver has become an essential component of modern leadership.
Notwithstanding the immense impact of the pandemic on the way we work, live and plan our lives, the world has long been in a state of flux due to the transformative impact of new technologies and increased digitisation.
Today, business is IT and IT is business. Even in the public sector, a state’s ability to harness powerful technologies and digitise its interactions with citizens plays a huge role in how effectively that state can deliver its services.
RELATED: Rethinking leadership in the post-COVID era
Collectively we will invest $1.8-trillion in digital transformation initiatives this year alone, a 17.6% increase over 2021 and a huge jump from the collective $1.18-trillion we spent on such initiatives in 2019. And with spending to continue at a compound annual growth rate of 16.6% over the next five years, the role of digital transformation has never been greater.
And yet, too often the impact and promise of digital transformation initiatives is undermined by a lack of understanding of the role technology plays.
Led by digital dodos
The truth is, many companies are led by executive teams with a limited understanding of technology. One study found that only 7% of large companies have digitally-savvy executive teams.
While not every CEO needs to be fluent in Python or be able to articulate the inner workings of quantum computing, a basic understanding of technologies and their function is essential in today’s digitally-led economy.
When business leaders are out of touch with technology, it can lead to some embarrassing situations. Just think back to an ageing US congressmen asking Google representatives why negative stories appear when they enter their names into Google’s search bar. Or former IBM president Thomas J Watson’s 1940s comment that “there is a world market for about five computers.”

Cathy Smith, Managing Director at SAP Africa
We may have a quiet laugh at the absurdity of such comments, but when they emanate from the mouths of company leadership at a time when sound technological investment can literally mean the difference between success and failure, they lose their comic touch.
Companies are investing more money, resources and manpower in technology and digital transformation than ever before. When the value of that investment is not clear to the executives leading the business, it’s unlikely that companies will achieve a positive return on investment or solve the challenges they seek to overcome.
More importantly, the lost opportunity cost could set back companies’ growth and innovation plans for years, leaving them lagging competitors at a time when competition is at a peak.
Turning tech investment into executive action
A sad but inescapable truth is that those controlling the purse strings – whether they be investors, boards of directors or finance ministers – will not become advocates of IT if they do not understand the value it creates.
Digital transformation projects that fail to realise value or experience severe cost and time overruns, can undermine the trust that decision-makers have in technology. This creates a disconnect between business and IT that hampers future digital transformation initiatives.
However, when executives do understand and see the value, and are clear on the application of technology in their own business to improve the lives of their customers, there is no limit to the innovation and growth they can unlock.
To start, focus on asking the right questions. Instead of wondering about which mix of cloud technologies is best, or what the scope of their IoT deployment needs to be, executives should focus on the business objectives they are trying to achieve.
“How can I remove friction from my customer experience?” or “how best do I respond to a new digital competitor to my business model?” are far better departure points for digital transformation than “which technologies should I acquire to be successful?”.
Once the objective is clear, business and IT need to collaborate to develop an effective implementation and change management plan driven from the top through middle management and across the organisation. A sustained campaign highlighting the value of the digital transformation project and what it means to business users, customers and the broader organisation can greatly assist with driving adoption of new tools and processes.
A CEO or CFO that is actively involved in the execution of the company’s digital transformation strategy and understands the close alignment between tech and business strategy can act as powerful role models to the rest of the organisation. It’s no surprise that some of the most successful digital transformation projects have hands-on involvement from the C-suite, who set the pace for how the business collaborates with IT.
Investing in training and skills development ensures every layer of the organisation – from the top floor to the shop floor – understands the value of the new tech-enabled capabilities and can apply the new tools effectively when performing their day-to-day work tasks.
Critically, executives need to establish a culture of continuous improvement and refinement where technologies, tools and processes are constantly fine-tuned to serve the precise needs of the organisation and its customers, partners and suppliers.
Whether you lead a nimble start-up, large enterprise or an entire nation, as a leader you need a well-developed understanding of the role technology can play in improving lives, developing new solutions to present challenges, and driving growth.
Gaining some technological nous is an essential component of successful modern leadership.
COVER IMAGE: International Director